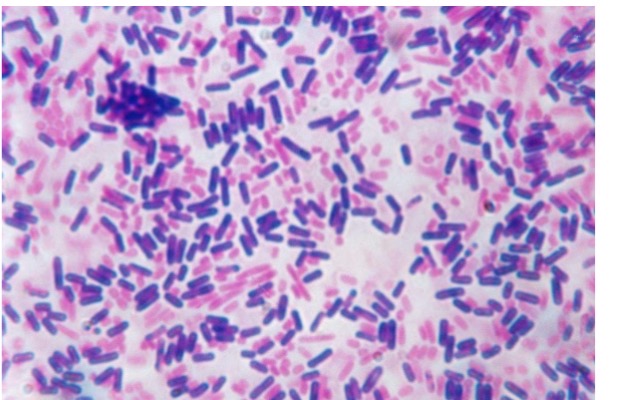
<p>Brightfield microscopy</p>
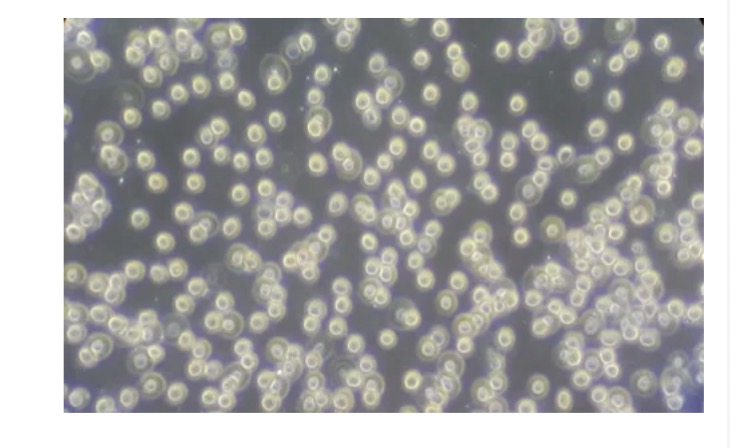
<p>Phase-contrast microscopy</p>
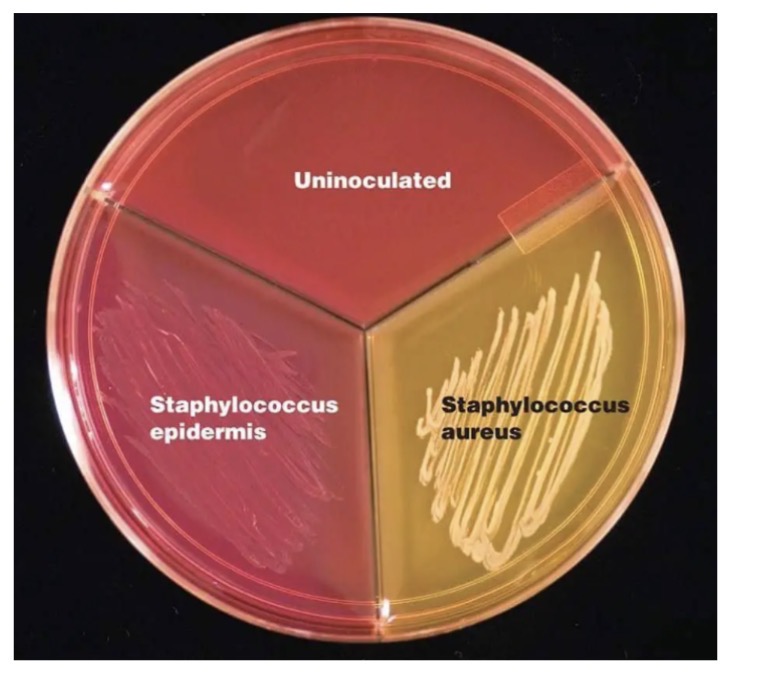
<p>MSA (Mannitol Salt Agar)</p>
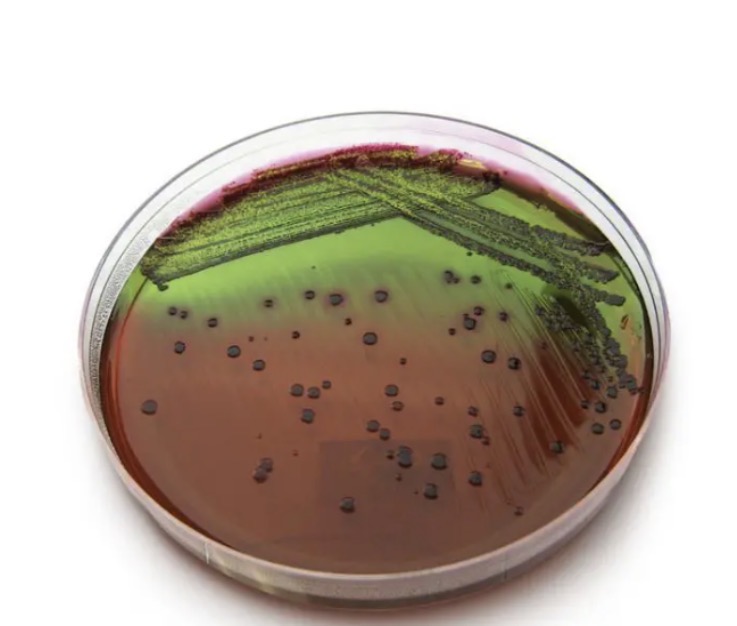
<p>EMB agar</p>
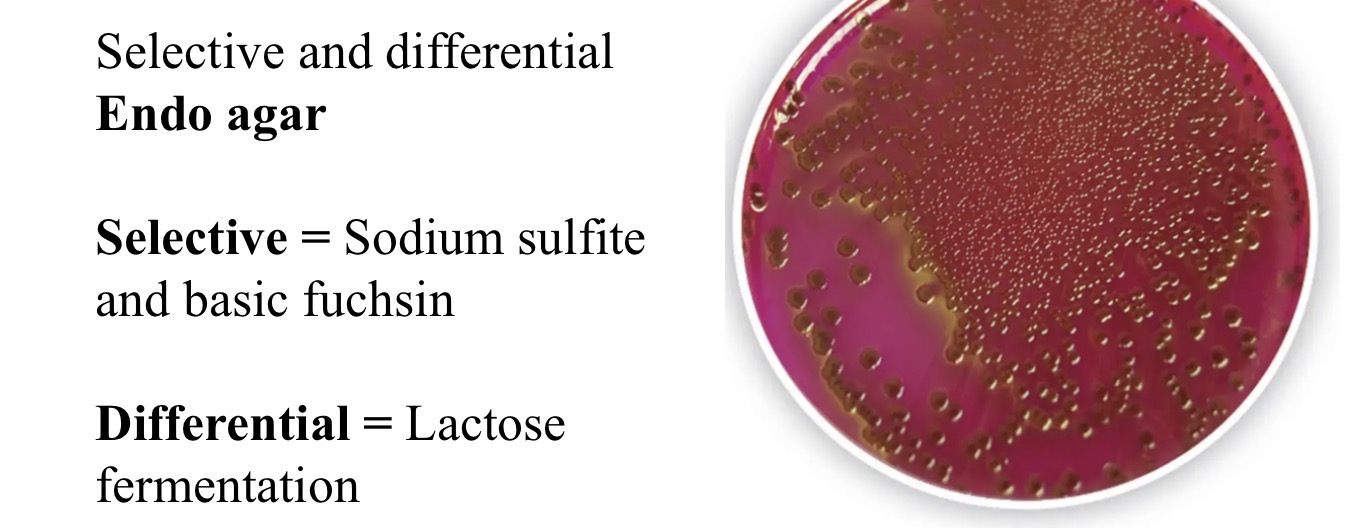
<p>Endo agar</p>
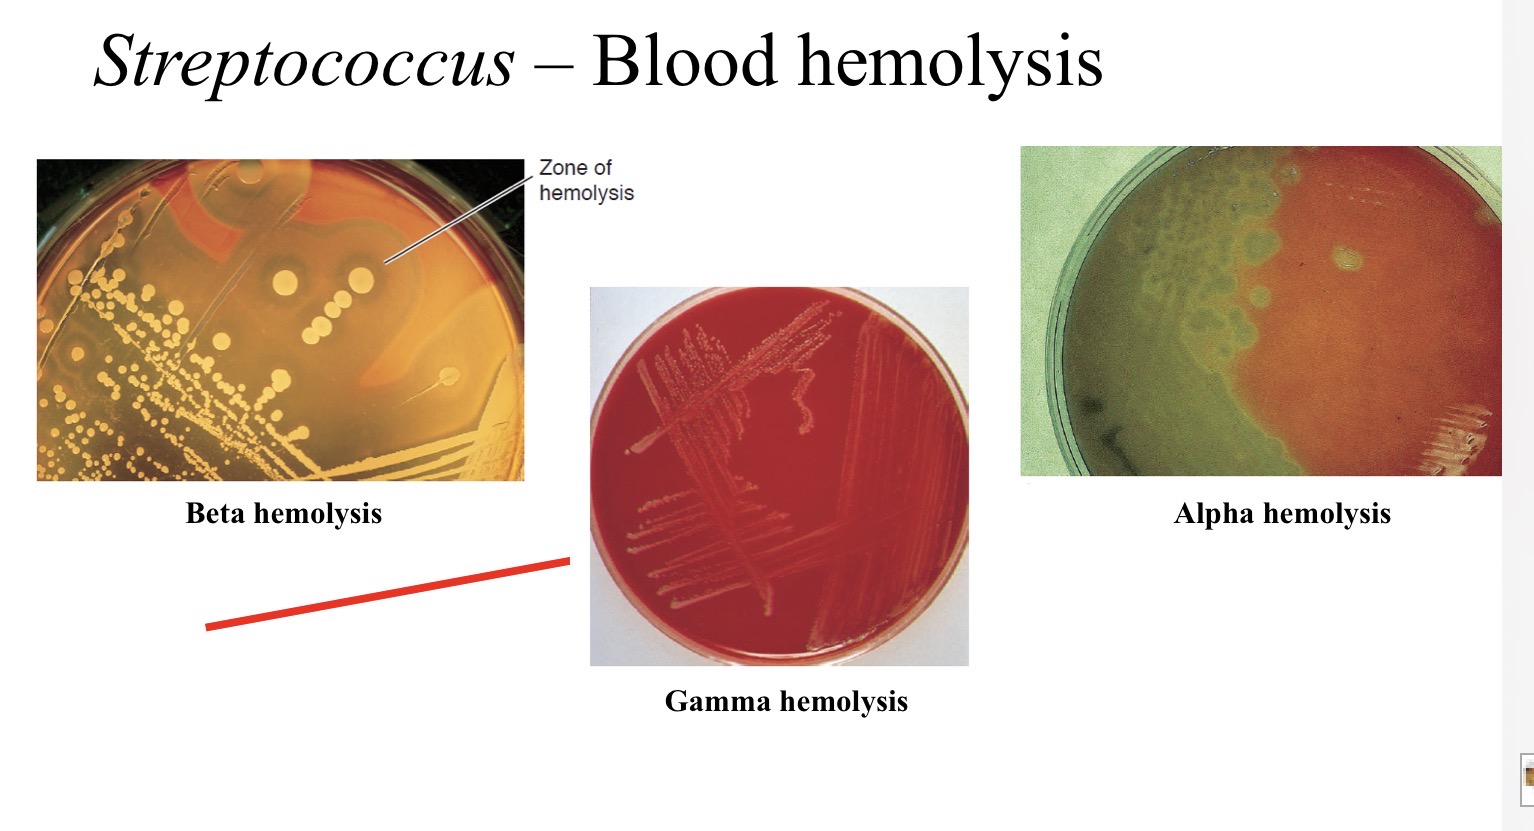
<p>Blood agar</p>
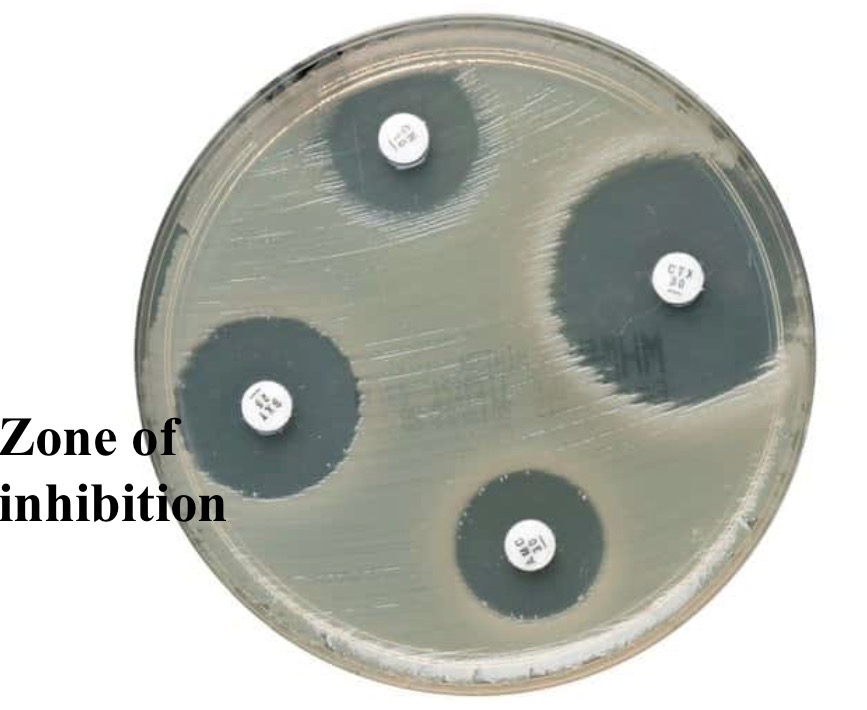
<p>Kirby-Bauer test</p>

1/73
Looks like no tags are added yet.
Name | Mastery | Learn | Test | Matching | Spaced | Call with Kai |
|---|
No analytics yet
Send a link to your students to track their progress
Microbiology Lab Practical Study Guide
Know media name, selectivity, differential properties, what is tested, organisms, and expected results (color, growth, zones)
Brightfield microscopy
Used for dead, stained cells with low contrast
Phase-contrast microscopy
Used for live, unstained cells with high contrast
Telescopic eyepiece
Aligns phase rings in phase-contrast microscopy
True motility
Directional movement of bacteria
Brownian motion
Random vibration of particles, not true movement
Streaming
Movement caused by fluid currents

Tetrazolium dye
Turns red where bacteria grow in motility media
Motility positive result
Growth spreads outward from stab line
Motility negative result
Growth stays along stab line

Gram stain results
Gram-positive = purple, Gram-negative = pink

Endospore stain
Detects bacterial spores

Acid-fast stain
Identifies Mycobacterium species

Capsule stain
Detects capsules, indicates virulence

Negative stain
Outlines cells without staining them
MSA (Mannitol Salt Agar)
Selective for Staphylococcus (high salt), differential for mannitol fermentation

MacConkey agar
Selective for Gram-negative bacteria, differential for lactose fermentation
EMB agar
Selective for Gram-negative, lactose fermentation; E. coli shows green metallic sheen
Endo agar
Differentiates lactose fermenters

TSI test
Tests sugar fermentation and hydrogen sulfide (H2S) production

Urease test
Tests urea breakdown; positive = pink

Indole test
Tests tryptophan breakdown; positive = red ring

Citrate test
Tests ability to use citrate as carbon source; positive = blue

Oxidase test
Tests for cytochrome c oxidase; positive = purple

Coagulase test
Identifies Staphylococcus aureus; positive = clot formation
Blood agar
Differentiates hemolysis: alpha (green), beta (clear), gamma (none)
Kirby-Bauer test
Measures antibiotic sensitivity via zones of inhibition

MPN method
Estimates bacterial count using dilution series

Anaerobic jar
Grows obligate anaerobes

Pipette types
Know different pipettes used in lab

T2 bacteriophage
Lytic phage that infects E. coli

Plaques
Clear zones showing bacterial lysis by phage
PFU/mL calculation
Plaques ร dilution รท volume
E. coli
Gram-negative, lactose fermenter
Pseudomonas
Gram-negative, non-lactose fermenter
Staphylococcus aureus
Gram-positive, MSA positive, coagulase positive
Staphylococcus epidermidis
Gram-positive, MSA negative, coagulase negative
Klebsiella
Gram-negative, citrate positive
Proteus
Gram-negative, urease positive

Catalase Test
What you look for:
Bubbles = Positive result
Oxygen gas is being released
The bacteria have catalase
No bubbles = Negative result
No oxygen produced
The bacteria do NOT have catalase
Staphylococcus (like S. aureus) โ Catalase positive
You will see bubbling
Streptococcus โ Catalase negative
You will see no bubbling
Thermal death point (TDP)
the lowest temperature at which a
bacterial population ties in 10 min.
Thermal death time (TDT)
the shortest time to kill bacteria at a
specific temperature.
โข Antibiotics
compounds that kill or inhibit bacteria.
Bacteriostatic
inhibits growth of bacterial cells but does not kill them.
Bactericidal (cidal = kill)
Agents that kill
bacterial cells
Disinfectants โ
Kills viruses and
bacteria on a surface, much
stronger than sanitizers.
Antiseptics
Lowers the number
of germs on a surface to a safer
level.
K/A (red slant / yellow butt)
Glucose fermentation only; slant reverts to alkaline (red) after glucose is used, butt stays acidic (yellow)
A/A (yellow slant / yellow butt)
Glucose + lactose and/or sucrose fermented; large acid production keeps entire tube yellow
K/no change (red slant / red butt)
No fermentation; organism uses peptones only (alkaline)
K/HโS (red slant / black butt)
No lactose/sucrose fermentation; glucose fermented + HโS produced
Cracked or lifted agar
Gas production from fermentation

Bacterial Morphology
Coccus

Bacteria Morphology
Bacillus
Bacteria Morphology


Cocci Arrangement
Coccus (single-celled)

Cocci Arrangement
Diplococci (occur in pairs)

Cocci Arrangement
Tetrad (group of 4 cocci)

Cocci Arrangement
Streptococci (chain-like morphology)

Cocci Arrangement
Staphylococci (grape-like cluster)
aerobes
respire (O2)
microaerophiles
respire (decreased O2)
faculatives
respire if O2 is available, ferment if not
aerotolerants
ferment only (tolerate O2)
anaerobes
ferment (often killed by O2)
psychrophiles
5-15, arctic waters
psychrotrophs
mesophiles that can grow at refrigerator temps
mesophiles
25-45, most bacteria, including human pathogens
thermophiles
45-70, soil, compost piles
hyperthermophiles
>75, hot springs
thermodurics
survive but do not grow at high temperatures
Isotonic
solute conc. same inside and outside the cell, water moves equally in both directions
Hypotonic
solute conc. higher inside the cell, water moves into cell
Hypertonic
solute conc. higher outside the cell, water moves out